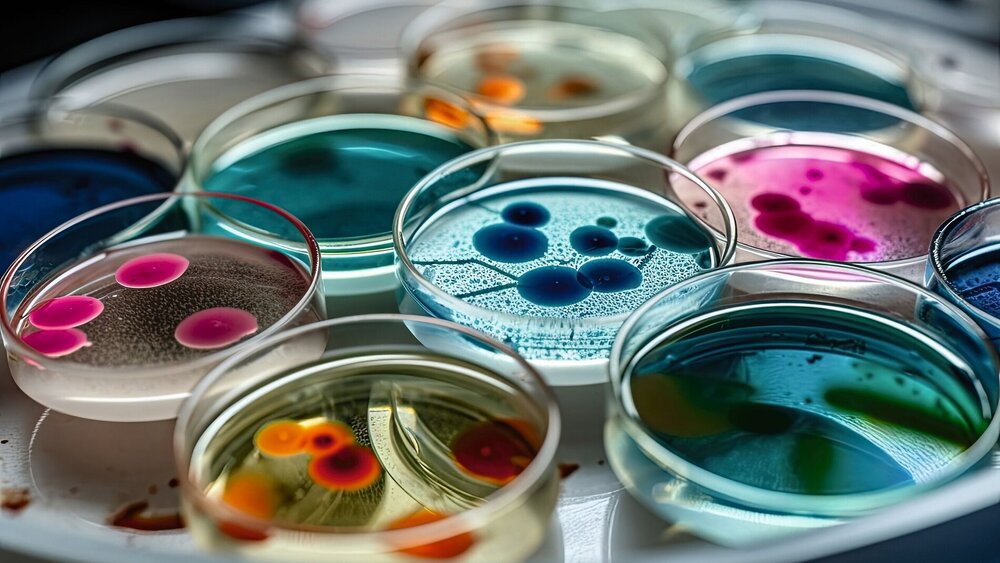

Come together: Registergesetz soll Datensilos knacken
Ohne medizinische Register wäre die Überprüfung von Behandlungsverfahren oder die Erforschung neuer Therapien nur schwer möglich. Sie sind essenziell für die Qualitätssicherung im Gesundheitswesen. Register sind eine komplexe Angelegenheit: Grundsätzlich versteht man darunter organisierte Systeme, in denen auf Basis einer zuvor festgelegten Fragestellung standardisiert Daten über sogenannte „Beobachtungseinheiten“ dokumentiert werden.
In der Medizin gelten laut einer Definition des Deutschen Netzwerks Versorgungsforschung (DNVF) neben Personen (etwa Krebserkrankte oder Organspender) und Gruppen (etwa Kliniken) auch materielle Dinge (etwa Arzneimittel) als Beobachtungseinheiten. „Dabei stellen Patientenregister eine bestimmte Patientengruppe, definiert durch eine gemeinsame Erkrankung, in den Mittelpunkt. Demgegenüber sind Medizinprodukteregister auf die Analyse und Bewertung von Medizinprodukten wie Implantaten ausgerichtet. Im Fokus von Arzneimittelregistern stehen Wirkung, unerwünschte Wirkungen und Komplikationen der eingesetzten Pharmakotherapie“, führt das DNVF aus. Medizinische Register können sich darüber hinaus in ihrer Zielsetzung unterscheiden: Während epidemiologische Register auf die Gesamtbevölkerung übertragbare Aussagen ermöglichen, erfassen klinische Register Merkmale von Patientinnen und Patienten einer oder mehrerer Versorgungseinrichtungen und sind demnach regional begrenzt.
Zweck, Aufbau und Datenverwaltung sind in den Registern unterschiedlich geregelt und es gibt bisher keine allgemeingültigen Leitlinien für die Bewertung der Qualität eines Registers. Forschende in Deutschland bemängeln außerdem: Medizinische Register hierzulande sind nicht schlau verknüpft – weder untereinander noch mit anderen Datenquellen etwa auf europäischer Ebene. Oft ist in diesem Zusammenhang von Datensilos die Rede. Das liegt unter anderem im föderalen Aufbau des deutschen Gesundheitssystems begründet. Hinzu kommt das Fehlen einer koordinierenden Stelle, die die Daten nach einheitlichen Kriterien sowohl qualitativ als auch technisch strukturiert. Und: Neben der Finanzierung eines neu aufgestellten Registerwesens müssten die rechtlichen Grundlagen für die Auswertung der Daten geklärt werden.
Erste konzeptionelle Ideen
Hier will das Bundesgesundheitsministerium (BMG) mit dem Registergesetz Fortschritte machen. Das Vorhaben ist schon länger ein Thema im BMG. Bereits 2019 hatte der damals zuständige Bundesminister Jens Spahn ein Gutachten beim BQS Institut für Qualität und Patientensicherheit und bei der Technologie- und Methodenplattform für die vernetzte medizinische Forschung (TMF) in Auftrag gegeben. Im Oktober 2021 erschien das 296 Seiten umfassende Papier unter dem Titel „Gutachten zur Weiterentwicklung medizinischer Register zur Verbesserung der Dateneinspeisung und -anschlussfähigkeit“. Es dient auch dem inzwischen SPD-geführten Ministerium als wichtige Arbeitsgrundlage für das Gesetzesvorhaben.
Gleich zu Beginn konstatiert das Registergutachten kurz und knapp: „Es besteht keine Übersicht über die medizinisch-wissenschaftliche Registerlandschaft in Deutschland.“ Aus diesem Grund wurde im Rahmen des Gutachtens eine Datenbank aufgebaut, die Informationen über Laufzeit, thematische Schwerpunkte und Ziele der zum damaligen Zeitpunkt 356 relevanten Register zusammenträgt. Basierend auf der Analyse der aktuellen Registerlandschaft in Deutschland formulierten die Gutachterinnen und Gutachter zehn Handlungsempfehlungen. Das BMG leitete daraus erste konzeptionelle Überlegungen ab, die im Gesetzentwurf im Herbst ihren Niederschlag finden sollen.
Bei den „Registertagen 2023“ im Mai in Berlin stellte das BMG Eckpunkte für das Gesetz vor. Folgende Regelungen sind angedacht:
Einrichtung einer Zentralstelle für medizinische Register (ZMR): Hier soll ein Verzeichnis über medizinische Register in Deutschland geführt werden. Die Registrierung ist freiwillig. Außerdem soll die ZMR beraten und die Vernetzung der Register und der Forschenden untereinander fördern, indem sie Wissen bündelt und Instrumente zur Erleichterung des Registeraufbaus und der -weiterentwicklung in Abstimmung mit den Registerbetreibenden entwickelt. Perspektivisch könnte die ZMR auch die Anbindung der medizinischen Register an den Europäischen Gesundheitsdatenraum (EHDS) unterstützen.
Schaffung von bundeseinheitlichen Rechtsgrundlagen für die Erhebung und Verarbeitung von Daten: Das BMG zieht in Erwägung, für alle unter das Gesetz fallenden Register eine Datenerhebung mit einer einfachen Zustimmung der Patientinnen und Patienten zu erlauben. In manchen Fällen soll es eine Datenerhebung auch ohne Einwilligung und mit Widerspruchsrecht geben. Dabei beruft sich das Ministerium auf eine Aussage im Registergutachten, wonach es laut DSGVO aus Gründen des öffentlichen Interesses in Bereichen der öffentlichen Gesundheit erlaubt sei, besondere Kategorien personenbezogener Daten auch ohne Einwilligung der Betroffenen zu verarbeiten.
Erleichterung eines direkten Datenlinkages: Den Registern soll es ausdrücklich erlaubt sein, die Krankenversichertennummern (KVNR) zu erheben und in einer einzurichtenden Vertrauensstelle zu speichern. Dies schlägt das BMG als Einstieg in die sukzessive Einführung einer Forschungskennziffer vor, die registerübergreifende Auswertungen ermöglicht.
Eine Harmonisierung der medizinischen Register in Deutschland könnte die Datenbasis für eine patientenorientierte Forschung enorm erweitern und bestehende Therapien verbessern. Vorher müssen jedoch noch dicke Bretter gebohrt werden, insbesondere, was die technische Infrastruktur, die Finanzierung und Datenschutzfragen angeht.